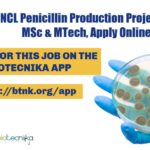
CSIR-NCL Pune Associate

Home Search
biology - search results
If you're not happy with the results, please do another search
THSTI COVID-19 Project Associate Jobs, MSc & MTech Apply Online
THSTI Project Associate Jobs, MSc & MTech Apply Online
THSTI Project Associate Jobs, MSc & MTech Apply Online. M. Sc./ M. Tech. in Life Sciences/...
Biotecnika Times Newsletter 30.09.2021 Govt SSC Recruitment, Govt BCG Vaccine Lab, HPCL
Biotecnika Times - Govt SSC Recruitment, Govt BCG Vaccine Lab, HPCL
Govt SSC Staff Selection Commission Recruitment 2021- Download Biotecnika App to Apply
SSC Staff Selection...
NIAB Project Associate Jobs For MTech & MSc, Apply Online
NIAB Project Associate Jobs For MTech & MSc, Apply Online
NIAB Project Associate Jobs For MTech & MSc, Apply Online. National Institute of Animal Biotechnology...
Life Sciences Postdoctoral Fellows With Rs. 58,000 pm Pay at ACTREC
Life Sciences Postdoctoral Fellows With Rs. 58,000 pm Pay at ACTREC
Life Sciences Postdoctoral Fellows With Rs. 58,000 pm Pay at ACTREC. Candidates with relevant...
Project-JRF Job at RCB – Online Applications From MSc & MTech
Project-JRF Job at RCB - Online Applications From MSc & MTech
Project-JRF Job at RCB - Online Applications From MSc & MTech. Eligible candidates can...
Evaluation of Drugs Project Recruitment at ICMR-NIRRH, Apply Online
NIRRH Project Vacancy - Life Sciences / Microbiology/ Biotech Apply
NIRRH Project Vacancy - Life Sciences / Microbiology/ Biotech Apply. NIRRH recruitment for MSc candidates....
Pachhunga University College, Project Assistant Recruitment For MSc Life Sciences
Pachhunga University College, Project Assistant Recruitment For MSc
Pachhunga University College, Project Assistant Recruitment For MSc. MSc Life Sciences, Microbiology, Biotechnology, Biochemistry, Zoology, Molecular and...
Bioinformatics Project Scientist Job at Punjab Agricultural University
Bioinformatics Project Scientist Job at Punjab Agricultural University
Bioinformatics Project Scientist Job at Punjab Agricultural University. PhD in Biotechnology/ Bioinformatics/ System Biology and Bioinformatics/ Computational...
ICGEB-JNU Ph.D. Programme 2021 Admission, Online Application Process
ICGEB-JNU PhD Programme 2021 Admission, Online Application Process
ICGEB-JNU PhD Programme 2021 Admission, Online Application Process. PhD Admissions 2021. ICGEB-JNU PhD Admission 2021. Interested and...
CSIR NCL Penicillin Production Project Job For MSc & MTech, Apply Online
CSIR-NCL Pune Associate Jobs, Online Application Process
CSIR-NCL Pune Associate Jobs, Online Application Process. NCL Pune is hiring MSc, BE, BTech & MTech Natural Sciences...
Govt SSC Staff Selection Commission Recruitment 2021, Online Application Process
SSC Staff Selection Commission Recruitment 2021, Apply Online
SSC Staff Selection Commission Recruitment 2021, Apply Online. MSc, BTech and BSc candidates apply. Botany, Zoology, Agriculture,...
Biotecnika Times Newsletter 28.09.2021 Pepsi Recruitment, DHR Women Scientists Fellowship
Biotecnika Times - Pepsi Recruitment, DHR Women Scientists Fellowship
CCMB PhD Program Admission January 2022 - Download Biotecnika App to Apply
CCMB PhD Admissions 2022 January...
CCMB PhD Program Admission January 2022 – Online Application Process
CCMB PhD Admissions 2022 January - Apply Online
CCMB PhD Admissions 2022 January - Apply Online. Check out the eligibility for the CCMB - Centre...
NIPGR Short Term Fellowship Project JRF Recruitment, Applications Invited
NIPGR Short Term Fellowship Project JRF Recruitment, Applications Invited
NIPGR Short Term Fellowship Project JRF Recruitment, Applications Invited. MSc Biotechnology/Molecular Biology/Bioinformatics/Computational Biology/Plant Breeding/ Life Sciences...
Biological Sciences Project JRF Job at IISER TVM, Applications Invited
Biological Sciences Project JRF Job at IISER TVM, Applications Invited
Biological Sciences Project JRF Job at IISER TVM, Applications Invited. IISER TVM is hiring Biological...